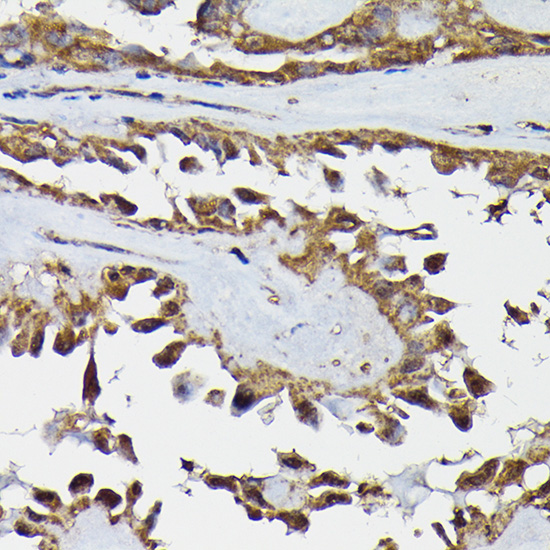

TRBP (TARBP2) Rabbit Polyclonal Antibody
Other products for "TARBP2"
Specifications
| Product Data | |
| Applications | IF, IHC, WB |
| Recommended Dilution | WB,1:500 - 1:2000 IHC,1:50 - 1:200 IF,1:50 - 1:200 |
| Reactivities | Human, Mouse |
| Modifications | Unmodified |
| Host | Rabbit |
| Isotype | IgG |
| Clonality | Polyclonal |
| Immunogen | Recombinant fusion protein containing a sequence corresponding to amino acids 1-366 of human TARBP2 (NP_599150.1). |
| Formulation | Buffer: PBS with 0.02% sodium azide,50% glycerol,pH7.3. |
| Concentration | lot specific |
| Purification | Affinity purification |
| Conjugation | Unconjugated |
| Storage | Store at -20℃. Avoid freeze / thaw cycles. |
| Stability | Shelf life: one year from despatch. |
| Predicted Protein Size | 36kDa/39kDa |
| Gene Name | TARBP2, RISC loading complex RNA binding subunit |
| Database Link | |
| Background | HIV-1, the causative agent of acquired immunodeficiency syndrome (AIDS), contains an RNA genome that produces a chromosomally integrated DNA during the replicative cycle. Activation of HIV-1 gene expression by the transactivator Tat is dependent on an RNA regulatory element (TAR) located downstream of the transcription initiation site. The protein encoded by this gene binds between the bulge and the loop of the HIV-1 TAR RNA regulatory element and activates HIV-1 gene expression in synergy with the viral Tat protein. Alternative splicing results in multiple transcript variants encoding different isoforms. This gene also has a pseudogene. |
| Synonyms | MGC124970; Prbp |
| Reference Data | |
Documents
| Product Manuals |
| FAQs |
| SDS |
{0} Product Review(s)
0 Product Review(s)
Submit review
Be the first one to submit a review
Product Citations
*Delivery time may vary from web posted schedule. Occasional delays may occur due to unforeseen
complexities in the preparation of your product. International customers may expect an additional 1-2 weeks
in shipping.






























































































































































































































































 Germany
Germany
 Japan
Japan
 United Kingdom
United Kingdom
 China
China